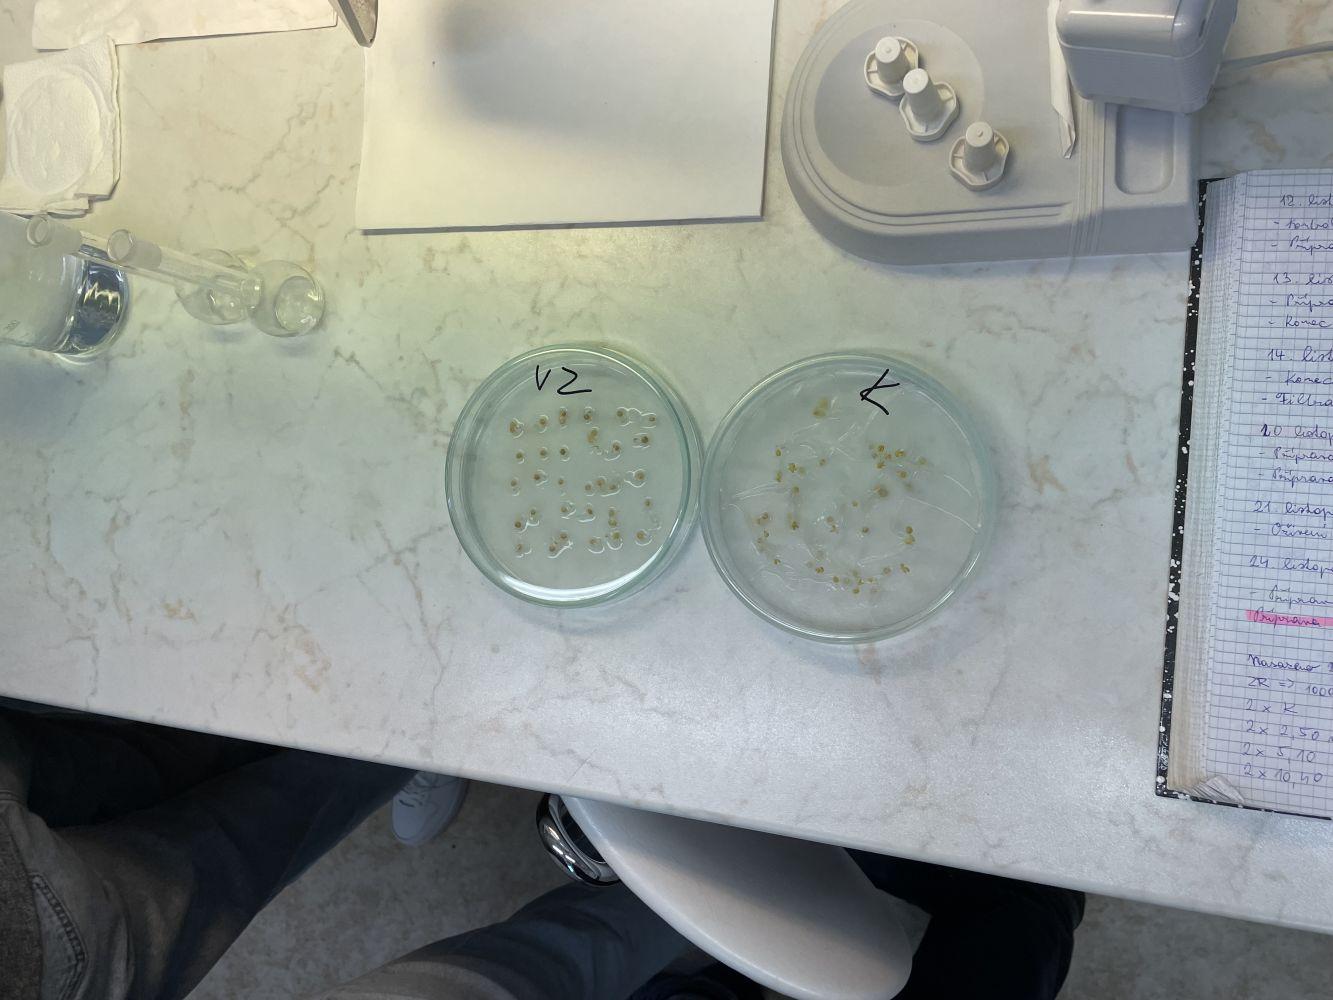

Na skok v ekotoxikologické laboratoři …
V rámci předmětu Biodegradace a ekotoxicita jsme se studenty dne 8. 12. 2025 navštívili ekotoxikologickou laboratoř na Státním zdravotním ústavu (SZÚ) Praha, kde nás přivítala paní Ing. Martina Wittlerová. Akreditovaná laboratoř SZÚ provádí akvatické a terestrické zkoušky ekotoxicity. Pro akvatické zkoušky (matrice např. výluh z odpadu) se používají chlorokokální řasy (Desmodesmus subspicatus), perloočky (Daphnia magna), bioluminiscenční bakterie (Aliivibrio fischeri) a semena hořčice bílé (Sinapis alba). V rámci terestrických testů (matrice např. zeminy anebo pevný odpad) se provádí test na salátu (Lactuca sativa). Zcela specifické jsou akutní testy toxicity na embryonálních stádiích dania pruhovaného (Danio rerio), které si laboratoř zajišťuje sama díky intenzivně udržovaným jedincům této kaprovité ryby. Přeživší jedince si laboratoř uchovává jako zelený design v chovné místnosti anebo je prezentuje veřejnosti v rámci akce Dnů otevřených dveří.
Děkujeme ekotoxikologické laboratoři SZÚ za tuto možnost seznámit se s laboratorní praxí a paní Ing. Wittlerové za přiblížení zajímavé práce se zkušebními organismy.